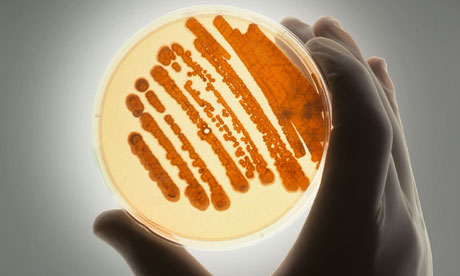
Petrie dish with bacteria in growth medium

There's no denying that universities are engines for economic growth and contribute to building a skilled workforce. But with the higher education sector facing huge financial and structural changes and juggling many competing priorities, where should universities be focusing their energies in the years ahead?
In a recent interview, John Cridland, director-general of the CBI (Confederation of British Industry), said there are three main areas universities need to work on: part-time provision and funding; developing sophisticated relationships with business; and allowing companies to be more involved in curriculum design and creating respected vocational qualifications.
Cridland – speaking with his business hat on – reminds the sector that universities are employers and businesses too, and therefore play a central role in economic growth. His description of students as 'customers' has not impressed many in the sector. But with universities the UK's fifth biggest export sector, Cridland points out, how can they make the most of this potential? And where does the responsibility for economic growth really lie – with vice-chancellors, academics, politicians, or business itself?
A growing (or repairing) economy needs both the innovation and output of academic research, and the skills and employability of graduates. In this live chat, we're interested in discussing how universities can strike the right balance between the two. Ahead of two Guardian fringe debates on 'Universities and Growth' at this year's Liberal Democrat and Labour party conferences, we want to kick off debate and hear your thoughts on the subject.
So join our live chat in the comments below on Friday 6 September from 12-2pm BST to discuss:
• Role of universities in stimulating economic growth
• Strengthening ties between research and industry
• Debate around the skills and employability agenda
• Curriculum design and vocational versus academic
• Funding and policy reforms
You can also follow the debate live on Twitter using the hashtag #HElivechat
Panel
Luke Georghiou is a professor and vice-president for research and innovation at the University of Manchester. He also sits on the executive management group of the N8 Research Partnership. @lukegeorghiou
Anna Vignoles is professor of education at the University of Cambridge. @AnnaVignoles
Alex Bols is executive director of the 1994 Group. @alexbols
Libby Hackett is chief executive of University Alliance. @UniAlliance
Jayne Mitchell is director of research, development and partnerships at QAA. @QAAtweets
Vivienne Stern is head of political affairs at Universities UK. @viviennestern
Dom Anderson is vice president (society and citizenship) at the NUS. @DomAnderson_1
Martin Howarth is head of engineering and mathematics at Sheffield Hallam University.
Adam Powell is head of enterprise and local partnerships at Bath Spa University.
This content is brought to you by Guardian Professional. Looking for your next university role? Browse Guardian jobs for thousands of the latest academic, administrative and research posts







